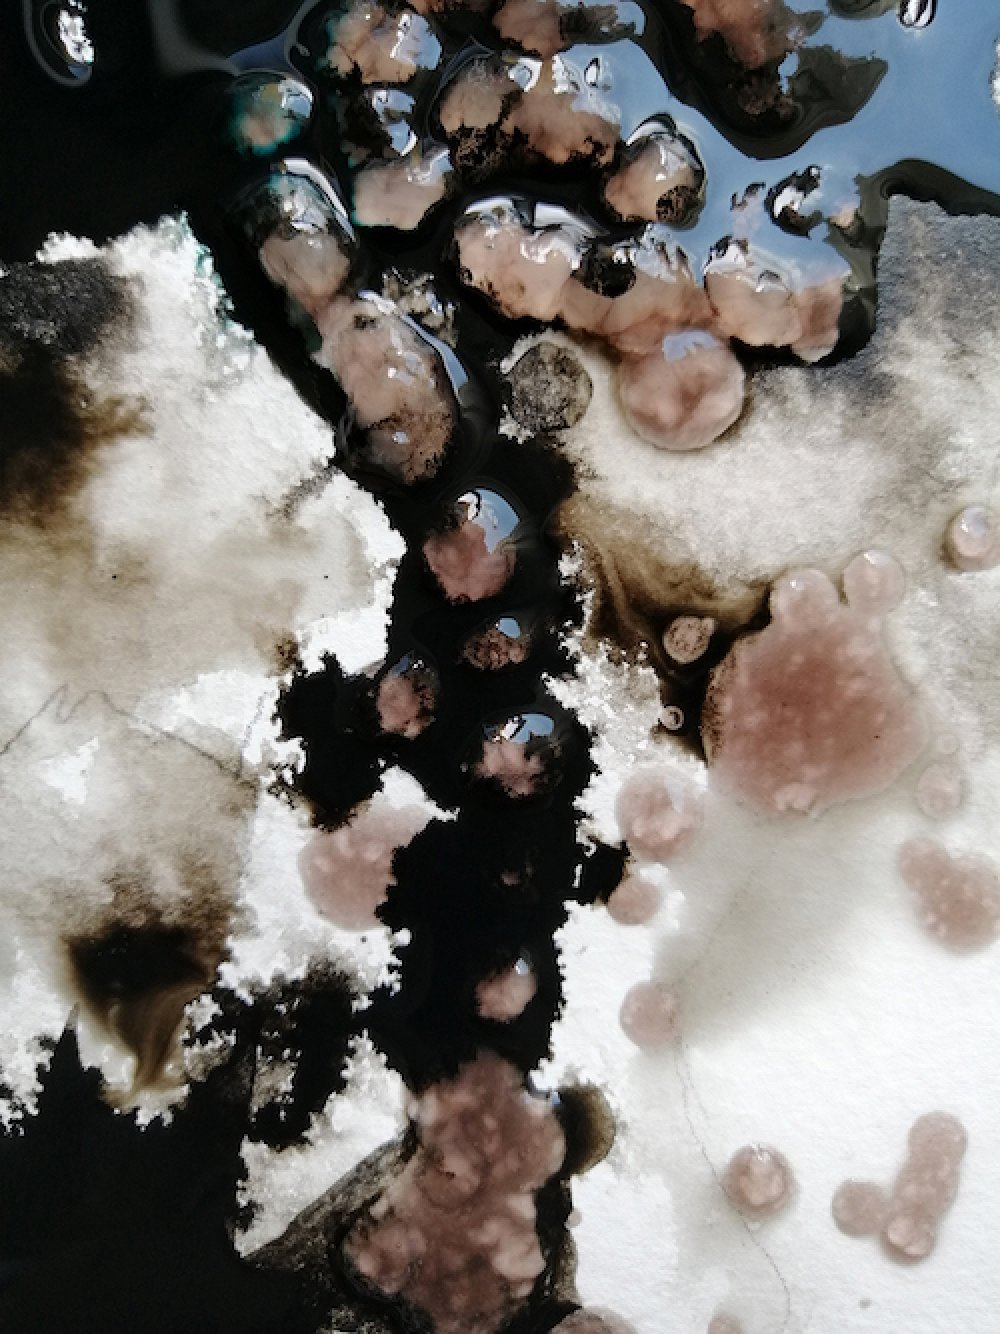
Mürekkep, Damla Katuk

Akademik ve sanatsal çalışmalarını mimarlık disipliniyle ilişkili olarak sürdüren Damla Katuk, İş Dışı konuğumuz oldu.

Söyleşide yer alan çalışmalar, Damla Katuk'un kişisel arşivine aittir.
Öncelikle kısaca sizi tanıyarak başlayalım.
1990 yılında İstanbul’da doğdum. Bir durumdan edindiğim çoklu duyusal, algısal, duygulanımsal, duygusal, doğrudan, içsel ve mekânsal deneyimi, mimari fenomenolojik yaklaşımla kavramsal, zamansal, geçirgen, dönüştürücü ve çağrıştırıcı bir deneyim süreci içerisinden geçirerek, keşfettiğim ve ilişkilendirdiğim özellikleri eskiz, sulu boya, mürekkep ve çizim aracılığıyla ifade etmeye çalışıyorum.

Sulu Boya, Damla Katuk
Eğitim süreciniz ve mimarlık kariyerinizden bahsedebilir misiniz?
İlk, orta ve lise eğitimlerimi İstanbul’da, lisans eğitimimi Erciyes Üniversitesi Mimarlık Fakültesi Mimarlık Bölümü’nde tamamladım. Farabi Değişim Programı ile 1 yıl Yıldız Teknik Üniversitesi Mimarlık Fakültesi Mimarlık Bölümü’nde eğitim aldım. Son sınıfta arkadaşlarımla katıldığımız Taç Vakfı 2010-2011 Öğretim Yarıyılı Mimarlık Öğrencileri Arası Proje Ödülü yarışmasında teşvik ödülü aldık. Lisans eğitimime devam ederken Erciyes Üniversitesi Güzel Sanatlar Fakültesi’nden seçmeli dersler alarak, ulusal ve uluslararası çalıştaylara, atölyelere ve sergilere katılarak mimarlık eğitimime çeşitli katkılar sağladım.
Mezun olduktan sonra mimarlık pratiği içerisinde yer almaya başladım. Çeşitli mimarlık ofislerinde, farklı ölçeklerdeki yapıların uygulama, avan, rölöve, restitüsyon, restorasyon, tasarım, detay ve sunum projelerinde çalıştım.
Yüksek lisans eğitimimi Fatih Sultan Mehmet Vakıf Üniversitesi Lisansüstü Eğitim Enstitüsü Mimarlık Anabilim Dalı’nda tam burslu olarak Prof. Dr. Emine Köseoğlu danışmanlığında tamamladım. Lisansüstü eğitim sürecimde bilimsel araştırma projeleri (BAP ve TÜBİTAK) ve atölyeler içerisinde yer aldım. Tez danışmanım ve proje yürütücüm ile birlikte yüksek lisans tezimden ve araştırma projelerinden uluslararası bilimsel araştırma makaleleri ürettik.
Bugüne kadar mimarlık alanında mesleki uygulama, akademik, bilimsel araştırma, sanat, tasarım ve diğer araştırma geliştirme çalışmaları içerisinde yer aldım. Yıldız Teknik Üniversitesi Mimarlık Fakültesi Mimarlık Bölümü'nde yarı zamanlı öğretim görevlisi ve mimari tasarım stüdyosu yürütücüsü olarak; İstanbul Rumeli Üniversitesi Mimarlık ve İç Mimarlık bölümlerinde yarı zamanlı temel tasarım stüdyosu yürütücüsü olarak görev almaya devam etmekteyim.

Sulu Boya, Damla Katuk
Mimarlıktan farklı uzmanlık alanlarına geçiş yapma fikri nasıl oluştu? Neydi size bu kararı verdiren?
Mimarlık pratiğine devam ederken eş zamanlı olarak KAFKAOKUR dergisi ekibinde çizerlik ve yazarlık yapmaya başladım. Mimarlık eğitimi sürecimde disiplinler arası çalışmalar içerisinde yer aldım. Sulu boya, eskiz, kara kalem, yağlı boya, illüstrasyon, moda tasarım, modlaj, fotoğrafçılık, serbest resim, gölge ve perspektif gibi seçmeli dersleri aldım. Mimarlık disiplinin yanında resme ve edebiyata ilgim hep vardı. Bu nedenle mimarlık alanında disiplinler arası ve teorik bilgi birikimimi çoğaltmak, çok yönlü deneyimler edinmek ve yeni çalışmalar yapabilmek amacı ile akademik ve sanatsal çalışmalara yönelmeye başladım. Akademik ve sanatsal çalışmalarım mimarlık disiplini ile ilişkili devam ediyor.
Mürekkep, Damla Katuk
Tüm bu üretimlerde mimarlığın etkisi nasıl hayat buluyor?
Bu çalışmaların temelinde genel olarak aldığım kapsamlı mimarlık eğitimi var diyebilirim. Birinci sınıfın ilk yarıyılında mimari tasarım stüdyosu dersinde Küçük Prens (Antoine de Saint-Exupéry), Görünmez Kentler (Italo Calvino), Mekânın Poetikası (Gaston Bachelard) gibi kitapları okuduk. Bu başlangıç benim kavramsal, yaratıcı ve disiplinler arası düşünme, soyutlama, bilgiyi dönüştürme, dönüştürücü ve içsel deneyimi anlama, keşfetme ve ifade etme, çizimle birlikte el-göz-beyin koordinasyonumu geliştirme sürecime katkı sağladı. Özetle, mimarlık eğitimi bana bir mekânı ya da durumu farklı dinamikleri ile çok boyutlu algılayabilme, anlayabilme, analiz edebilme, karşılaştırabilme, değerlendirebilme ve tasarlayabilme becerisi kazandırdı. Mimarlık, bu özellikleri ile yeni çalışmalarımda hayat buluyor.

Sulu Boya ve Mürekkep, Damla Katuk
Pek çok uluslararası makaleleriniz mevcut. Genel olarak hangi konuların çıktısı oluyor bu makaleler?
Bu makaleler yüksek lisans tezimin, bilimsel araştırma projelerinin ve lisansüstü seçtiğim derslerin çıktılarıdır. Çalışmalarda genel olarak su, biyofili, biyofilik tasarım, biyofilik mimarlık, algı, duygulanım, duyular, duygu, mekân, mimari mekân, çağdaş mimarlık örnekleri, çevresel psikoloji, tasarım gibi anahtar kelimelere odaklanarak ve David Seamon'ın fenomenolojik perspektiflerine göre uyarlanmış karma nitel araştırma deseninde mimari fenomenolojik eksenli bütüncül çoklu durum çalışması yöntemi ile Biyofilik Yaklaşımla Suyun Mekânda Algısal ve Duygulanımsal Boyutları: Çağdaş Mimarlık Örnekleri’nde danışmanım ile birlikte irdeledik. Bu araştırma Fatih Sultan Mehmet Vakıf Üniversitesi Bilimsel Araştırma Projeleri Koordinatörlüğü Birimi tarafından 22022B1Ç05D proje numarası ile ve Türkiye Bilimsel ve Teknolojik Araştırma Kurumu (TÜBİTAK) 1002-B Acil Destek Modülü tarafından 222K102 proje numarası ile desteklenmiştir.
Mimarlık dışındaki uzmanlık alanlarınıza geçelim... Sulu boya; hem çocuklara dersler hem yetişkinlere atölyeler veriyorsunuz. Sulu boyaya ilginiz nasıl başladı, nasıl gelişti?
Sulu boyaya ilgim ikinci sınıfta YTÜ Mimarlık Bölümü’nde Suluboya Teknikleri dersini seçmemle başladı. Bu derste öğrendiklerimi eskiz ve teknik resim ile birleştirerek diğer derslerde kullandım. Özellikle mimari tasarım sürecinde ve jüri sunum aşamasında, sulu boya tekniği ile fikirlerimi daha iyi ifade edebildiğimi gördüm. Bu nedenle sulu boya tekniğine daha fazla odaklandım. Mimarlık alanında katıldığımız bir yarışmada iki ve üç boyutlu çizimlerin yanında, paftalarda sulu boya tekniğini de kullandık. Dergi ekiplerine çizer olarak dahil olduğum zamanlarda sulu boya tekniğini kullanmaya devam ettim. Sonra eskiz ve sulu boya atölye yürütücülükleri başladı.

Mürekkep, Damla Katuk

Sulu Boya, Damla Katuk
Tabii bununla bağlantılı olarak bir de çizerlik tarafınız var. Çeşitli dergilerde çizerlik yaptınız. Çizerlik ve mürekkep çalışmalarınızı kısaca anlatabilir misiniz?
Eskiz yapmaya mimarlık eğitimi ile başladım. Bir süre sonra KAFKAOKUR ile yollarımız kesişti ve ekibe dahil oldum. Sonra çeşitli dergi ekiplerine de dahil oldum. Dergiler bana öykü, deneme, şiir türünde bir edebi eser ya da bir tema hakkında bilgi verirlerdi. Ben de bana verilen bilgiyi kavramsal, dönüştürücü ve çağrıştırıcı bir deneyim sürecinden geçirerek çizimler yapardım. Derginin genel yayın yönetmeni, editörü bazen de edebi eser sahibi ile görüşerek sulu boya, mürekkep, eskiz ya da dijital çizim teknikleri ile tasarladığım görseli geliştirirdim.

Sulu Boya ve Mürekkep, Damla Katuk
Bir de yazarlık yönünüz var. Hangi konularda ne tarz yazılar yazıyorsunuz?
Çizerlik yönüm yazarlık yönüme göre daha ağır basıyor diyebilirim. Franz Kafka’nın edebi eserleri hakkında bazı deneme türünde çalışmalarım var. Bu denemelerde de ağırlıklı olarak çizimler metne eşlik etti.

Mürekkep, Damla Katuk
Kafka eserleri üzerine çizim çalışmalarınız var. Kafka'ya ilginiz nereden geliyor? Kafkaeskiz başlığı altında neler çiziyorsunuz? Benzer başka çalışmalarınız var mı?
Mimarlık bölümü okurken mimari proje 5 stüdyosunda, Franz Kafka için fenomenolojik bir deneyim aracılığıyla disiplinler arası bir müze tasarımı istenmişti. Tasarım sürecine Franz Kafka’nın biyografilerini, kitaplarını, günlüklerini, mektuplarını okuyarak ve ilgili filmleri izleyerek başladık. Kafka’nın metinlerinden ilham alarak, tasarımlarımızı farklı temsil yöntemleri ile mekânlara dönüştürdük. Bu mimari tasarım stüdyosu hakkında daha fazla bilgi için Prof. Dr. Beyhan Bolak Hisarlıgil’in “Franz Kafka in the design studio: A hermeneutic-phenomenological approach to architectural design education” başlıklı makalesini inceleyebilirsiniz. Benim Franz Kafka’nın edebi eserlerine ilgim bu şekilde başladı. Kafka’nın edebi eserlerinden ilham alarak ve esinlenerek, eserde edindiğim mekânsal deneyimlerimi eskiz tekniği kullanarak kendime göre ve amatörce çizimlere dönüştürmeye başladım. Bu yöntemi seçmemdeki en önemli neden, yazar Franz Kafka’ya ait el çizimleri ile de karşılaşmış olmamdı. Dolayısıyla benim düşüncemde Kafka ve eskiz, Franz Kafka’nın edebi eserlerindeki mekân betimlemelerini, kullanıcı-mekân ilişkilerini ve eskiz birlikteliğini barındıran fenomenal bir birleşimdi. Benzer başka bir çalışmam yok fakat bazı yeni fikirlerim var.

Eskiz, Sulu Boya ve Mürekkep, Damla Katuk
Kısa ve uzun süreli atölye yürütücülükleri de yapıyorsunuz. Hangi çalışmalarınız kapsamında oluyor genelde bu atölyeler, içerikleri nasıl gerçekleşiyor?
Bu atölyelerde belirlenen bir konu ya da temanın, eskiz ve sulu boya tekniği ile katılımcılar tarafından ifade edilmesi amaçlanmaktadır. Eğer tek atölye yürütücüsü varsa, organizasyon yetkilisi ile iletişim hâlinde kalarak ve bir temaya göre yeni atölye içeriği tasarlayarak öneride bulunuyorum. Birden fazla atölye yürütücüsü varsa, atölye içeriğine ortak karar veriyoruz. Her yeni atölye için o atölyeye özgü bir atölye içerik dosyası, görsel ve poster hazırlanıyor.

Sulu Boya, Damla Katuk
Üniversitelerde aldığınız görevler (verdiğiniz dersler) ile ilgili de bilgi verebilir misiniz?
Yıldız Teknik Üniversitesi Mimarlık Fakültesi Mimarlık Bölümü'nde yarı zamanlı öğretim görevlisi ve mimari tasarım stüdyosu yürütücüsü olarak Mimari Tasarıma Giriş (MTG), Mimari tasarım 1 (MT1) ve Suluboya Tekniği derslerinde görev alıyorum. İstanbul Rumeli Üniversitesi Sanat, Tasarım ve Mimarlık Fakültesi Mimarlık ve İç Mimarlık bölümlerinde yarı zamanlı tasarım stüdyosu yürütücüsü olarak Mimaride Temel Tasarım 1 ve Mimaride Temel Tasarım 2 derslerinde görev alıyorum.

Sulu Boya, Damla Katuk
Tüm bu alanlara bakınca; sizin için ne ifade ediyor; yazmak, çizmek, boyamak... Size en çok keyif veren ya da iyi hissettiren ne?
Çeşitli durumlarda edindiğim içsel, ilk-el, anlık ve çağrıştırıcı deneyimin çıktılarını, kendi çoklu duyusal, duygusal ve düşünce süzgecimden geçirerek keşfettiğim, anladığım özellikleri ve ilişkileri; eskiz, sulu boya ve mürekkep teknikleri aracılığıyla görsele dönüştürmeye çalışıyorum. Dönüştürücü ve içsel deneyim sırasında durumda mevcut olan çoklu duyusal parçaları ve metinleri, görsel çalışma ile araç olarak ilişkilendiriyorum. Özetle, bir durum aracılığıyla edindiğim içsel fenomenolojik deneyimi, çizim ile ifade etmeyi amaçlıyorum. Bu çizimlere nadiren yazdığım metinler eşlik edebiliyor. Sanırım bana en çok keyif veren, daha önce bilgimin olduğu ya da olmadığı bir durum ile karşılaşabilmek, içsel izlenim sürecimde çoklu bağlantılar kurabilmek ve keşfedebilmek, edindiğim dönüştürücü ve çağrıştırıcı deneyimi anlayabilmek ve çizerek, boyayarak ifade edebilmek.

Sulu Boya ve Mürekkep, Damla Katuk
Şu sıralar nasıl projeler var gündeminizde?
Şu sıralar doktora eğitimim için hazırlanıyorum. Yeni atölyeler tasarlıyorum. Bir sergi ve kitap projesi üzerinde çalışıyorum. Buna ek olarak, mimarlık pratiği ile olan bağlarımı koparmamak ve disiplinler arası çalışmalar ile bu bağları geliştirmek istiyorum.
Atölyelerinizden nasıl haberdar oluruz?
Atölye duyuruları öncelikle organizasyonu düzenleyen ekip tarafından yapılıyor. Organizasyon yetkilileri atölye duyurularını kendi web sayfalarında ya da sosyal medya hesaplarından yapabiliyor. Ben de yapılan atölye duyurusunu sosyal medya hesabımda paylaşıyorum.
Eklemek istedikleriniz...
Bu benim ilk söyleşimdi. Beni konuk ettiğiniz için size ve yolumun kesiştiği herkese teşekkür ederim.
Yorum Yazın